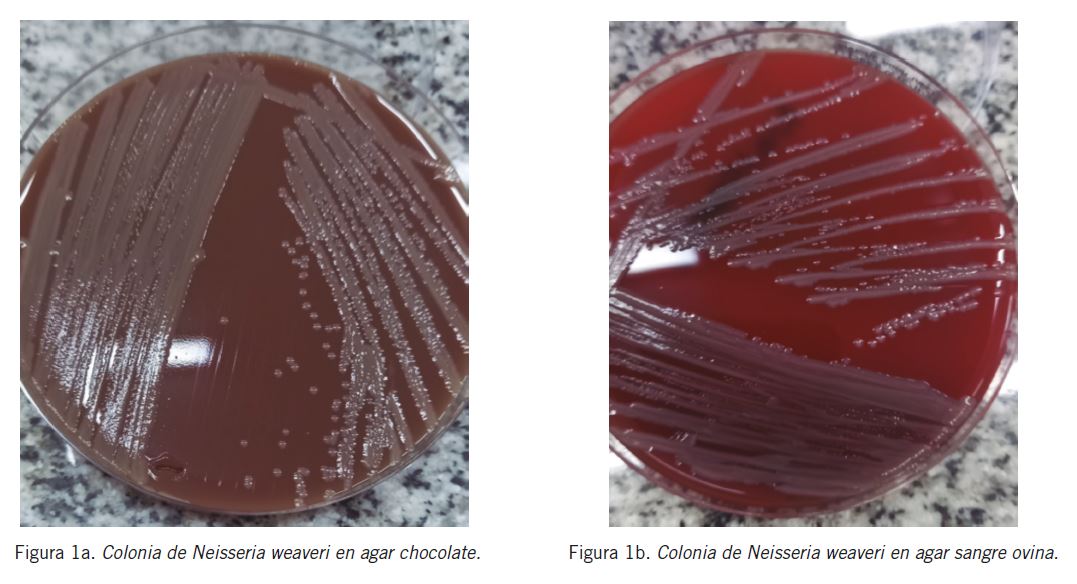

MICROBIOLOGÍA
Recepción: 03 Julio 2023
Aprobación: 31 Octubre 2023
Resumen: Las infecciones por mordeduras de perros y gatos presentan una etiología bacteriana mixta con microorganismos aerobios y anaerobios que provienen de la cavidad oral del agresor y, en menor medida, de la piel del agredido y el medio ambiente. Con mayor frecuencia se aíslan Pasteurella multocida, Pasteurella canis, Streptococcus spp., Staphylococcus spp., Corynebacterium spp., Capnocytophaga canimorsus y anaerobios. Si bien las infecciones por mordeduras de animales no son infrecuentes, algunos de los microorganismos implicados son excepcionales. Neisseria weaveri forma parte de la microbiota orofaríngea de perros y gatos; sin embargo, los casos comunicados debidos a mordeduras son escasos.
Palabras clave: Mordeduras de perro, Infecciones por mordeduras, Neisseria weaveri.
Abstract: Infections caused by dog and cat bites have a mixed bacterial etiology with aerobic and anaerobic microorganisms that come from the mouth of the offender and, to a lesser extent, from the skin of the victim and the environment. Pasteurella multocida, Pasteurella canis, Streptococcus spp., Staphylococcus spp., Corynebacterium spp., Capnocytophaga canimorsus and anaerobes can be frequently isolated. Although animal bite infections are not uncommon, some of the microorganisms involved are rare. Neisseria weaveri is part of the oropharyngeal microbiota of dogs and cats; however, reported cases due to bites are rare.
Keywords: Dog bites, Infections from bites, Neisseria weaveri.
Resumo: As infecções causadas por mordeduras de cães e gatos têm etiologia bacteriana mista com microrganismos aeróbicos e anaeróbicos que provêm da cavidade bucal do agressor e, em menor grau, da pele da vítima e do meio ambiente. Pasteurella multocida, Pasteurella canis, Streptococcus spp., Staphylococcus spp., Corynebacterium spp., Capnocytophaga canimorsus e aneróbios podem ser isoladas mais frequentemente. Embora as infecções por mordeduras de animais não sejam incomuns, alguns dos microorganismos envolvidos são raros. A Neisseria weaveri faz parte da microbiota orofaríngea de cães e gatos, porém são escassos os casos relatados como consequência de mordeduras.
Palavras-chave: Mordeduras de cães, Infecções por mordeduras, Neisseria weaveri.
Introducción
El aumento poblacional de las mascotas hizo que la importancia clínica de las mordeduras haya aumentado (1). La mayoría de las mordeduras son debidas a perros y se localizan con mayor frecuencia en manos, brazos y piernas (2). Los niños son especialmente propensos a las mordeduras de animales, especialmente en la cara y parte anterior del cuello (1) (2).
A pesar de que estas heridas pueden parecer inofensivas inicialmente, con frecuencia conducen a infecciones graves y complicaciones como sepsis, linfangitis, abscesos locales, artritis séptica y tenosinovitis, sobre todo en pacientes con comorbilidades: inmunosupresión, enfermedad hepática crónica, alcoholismo, asplenia, cáncer, tratamiento con corticoides y diabetes mellitus (1).
Las infecciones por mordeduras de perros y gatos presentan una etiología bacteriana mixta con microorganismos aerobios y anaerobios que provienen de la cavidad oral del agresor y en menor medida de la piel del agredido o del medio ambiente (2).
La boca del perro puede albergar hasta 64 especies diferentes de bacterias. Con mayor frecuencia se aíslan Pasteurella multocida, Pasteurella canis, Streptococcus spp., Staphylococcus spp., Corynebacterium spp., Capnocytophaga canimorsus, Weksella zoohelcum, Bacteroides spp., Prevotella spp. y Porphyromonas spp. La sinergia existente entre los microorganismos nombrados anteriormente hace que la infección sea más difícil de erradicar.
Si bien las infecciones por mordeduras de animales no son infrecuentes, algunos de los microorganismos implicados son excepcionales (1) (2) (3).
Las bacterias del género Neisseria spp. son comensales de la mucosa orofaríngea de perros y gatos sanos; en heridas por mordedura suelen aislarse Neisseria zoodegmatis (antiguo grupo EF-4b), Neisseria animaloris (antes CDC EF-4a), las que suelen estar subgnosticadas al identificarse erróneamente como Pasteurella spp. (3) (4) (5) (6) (7).
Neisseria weaveri, anteriormente llamada “grupo CDC M-5”, es un bacilo gram negativo aeróbico y forma parte de la microbiota orofaríngea de los perros y gatos. Es agente causal de diversas infecciones en el ser humano, como lesiones en la piel y los tejidos blandos, a consecuencia de mordeduras que pueden evolucionar a sepsis, formación de abscesos, artritis séptica, tenosinovitis y osteomielitis. También se la aisló de un lavado bronquial en un paciente con infección de vías respiratorias bajas (4) (5) (6) (7).
Como caso curioso, se aisló N. weaveri en una infección por mordedura de tigre junto con P. multocida (8).
En resumen, los casos comunicados de infecciones por este microorganismo son escasos.
El tratamiento empírico de elección para las mordeduras de perros y gatos es amoxicilina-ácido clavulánico, ya que esta combinación es activa contra la mayoría de los microorganismos implicados (2).
Es necesario evaluar, en cada caso, la necesidad de realizar un drenaje quirúrgico y aplicar profilaxis antitetánica y antirrábica. En pacientes inmunodeprimidos o esplenectomizados se requiere antibioticoterapia endovenosa al ingreso, por alto riesgo de sepsis (1) (7).
El objetivo de este trabajo fue presentar un caso de una infección por mordedura de perro por N. weaveri, un microorganismo poco frecuente.
Caso clínico
Se trata de un paciente de 2 años que ingresó a la guardia con herida contuso-cortante en su hemicara izquierda por mordedura de perro. La misma se extendía desde la región frontal hasta el maxilar inferior.
Se realizó curación, sutura de la herida y tratamiento con amoxicilina-ácido clavulánico 40 mg/kg/día durante cuatro días. Al cuarto día de evolución, por empeoramiento clínico y drenaje purulento espontáneo de la herida, se realizó cultivo de la secreción, limpieza de la misma y hemocultivos y se rotó a ceftriaxona 50 mg/kg/día y clindamicina 30 mg/kg/día. En total cumplió 10 días de tratamiento antibiótico.
En el cultivo de la secrecin desarrollaron en agar sangre ovina y agar chocolate colonias mucosas, grisáceas, no hemolíticas. El único microorganismo que desarrolló se identificó como N. weaveri (Fig. 1a) (Fig. 1b). El cultivo en anaerobiosis fue negativo y en los hemocultivos no se obtuvo desarrollo.
Por tratarse de un animal no vacunado se indicó vacunación antirrábica con esquema Zagreb (2-1-1).
Luego de 14 días de internación se otorgó el alta médica por buena evolución clínica y seguimiento por Cirugía Plástica Infantil.
Figura 1a y Figura 1b
Materiales y Métodos
Procesamiento de las muestras
La muestra se obtuvo por punción aspiración, se realizó coloración de Gram, se sembró en agar sangre de carnero al 5% y agar chocolate. Las placas fueron incubadas a 37 ºC en atmósfera con 5% de CO2, el caldo tioglicolato fue incubado a 37 ºC en atmósfera normal y una placa adicional de agar chocolate fue incubada en atmósfera anaeróbica a 37 ºC.
Los hemocultivos se incubaron durante 5 días en equipo automatizado BacT/Alert 3D.
Identificación
En la coloración de Gram de la punción aspiración se observó abundante reacción inflamatoria, pero no se observaron microorganismos.
En forma preliminar se realizó una coloración de Gram y las pruebas de catalasa y oxidasa desde las colonias.
En la coloración de Gram se observaron cocobacilos gram negativos; las pruebas de oxidasa y catalasa fueron positivas. La identificación final del microorganismo se realizó por espectrometría de masas (MALDI-TOF MS) con el equipo Vitek MS® (bioMérieux Argentina) según las indicaciones del fabricante. Se obtuvo un resultado con un 99,9% de confianza.
Discusión y Conclusiones
La realización del cultivo de la herida permitió el desarrollo e identificación de este microorganismo poco frecuente, lo cual refuerza la importancia de remitir las muestras para cultivo microbiológico y el trabajo interdisciplinario de todas las áreas involucradas.
Es remarcable y poco común la naturaleza monomicrobiana de este aislamiento.
Si bien CLSI y EUCAST no poseen puntos de corte para este microorganismo, Goldstein et al. determinaron una CIM 50 de 0,25 µg/mL y una CIM 90 de 0,5 µg/mL para amoxicilina-ácido clavulánico frente a Neisseria weaveri, con un rango de ≤0,03 a 0,25 µg/mL (9).
Si bien amoxicilina-ácido clavulánico es el antibiótico de elección, en este caso el paciente luego de cuatro días no evidenció mejoría. Esto podría deberse a la necesidad de drenaje de la herida que se realizó posteriormente con buena evolución clínica (10).
En esta instancia no se pudieron conservar los aislados para determinar la sensibilidad a los antimicrobianos.
Hubiera sido importante conocer este dato para dirigir correctamente el tratamiento y determinar los mecanismos de resistencia involucrados, si los hubiera, sobre todo en un microorganismo poco frecuente como éste.
La identificación y diferenciación por medio de métodos fenotípicos convencionales de bacilos gram negativos exigentes como los del género Neisseria y otros relacionados, es dificultosa, debido al escaso crecimiento y a la baja reactividad de las pruebas bioquímicas (11).
En la Tabla I se indican las características diferenciales del género Neisseria y otros microorganismos relacionados.

Tabla I
Características diferenciales del género Neisseria y otros microorganismos relacionados
Morf: morfología; Ox: oxidasa; Cat: catalasa; Pig: pigmento; dc-: diplococo gram negativo; b-: bacilo gram negativo; v: variable; G: glucosa; M: maltosa;L: lactosa; S: sacarosa; F: fructosa
Una fortaleza del laboratorio de Microbiología es la disponibilidad de nuevas tecnologías como la espectrometría de masas, que se posiciona como una herramienta muy eficiente en la identificación de este tipo de microorganismos poco frecuentes. En este punto es importante remarcar que, de acuerdo con indicaciones del fabricante, no hay limitaciones asociadas al taxón informado. Almuzara et al. demostraron la precisión en la identificación de especies de Neisseria de origen animal utilizando esta tecnología (11).
La limpieza y el desbridamiento de heridas producidas por mordeduras, la identificación de los pacientes que necesitan profilaxis contra la rabia, tétanos y la individualización de cada caso para la búsqueda de factores de riesgo son claves para evitar complicaciones graves.
Contribuciones como el presente trabajo pueden ayudar a valorar la participación de éste y otros microorganismos como potenciales agentes etiológicos de heridas asociadas a mordeduras de animales y a ajustar los tratamientos empíricos necesarios.
Fuentes de financiación
El presente trabajo fue realizado sin haberse recibido una financiación específica.
Conflictos de intereses
Los autores declaran no tener conflictos de intereses respecto del presente trabajo.
Correspondencia
Bioq. FLAVIA AMALFA.
Hospital General de Agudos “Parmenio Piñero”. Área Bacteriología. Servicio de Laboratorio. Av. Varela 1301. CP 1406. Ciudad Autónoma de Buenos Aires, Argentina.
Correo electrónico: flaviamalfa@hotmail.com
Referencias bibliográficas
1. Pardal-Peláez B, Sarmiento-García A. Microbiología de las infecciones causadas por mordeduras de perros y gatos en personas: una revisión. Rev Chilena Infectol 2021; 387 (3): 393-400.
2. Brook I. Microbiology and management of human and animal bite wound infections. Prim Care 2003 Mar; 30 (1): 25-39.
3. Shinha T. Cellulitis and bacteremia due to Neisseria weaveri following a dog bite. IDCases 2018 Mar 9; 12: 56-7.
4. Andersen B, Steigerwalt A, O Connor S, Hollis D, Weyant R, Weaver R, et al. Neisseria weaveri sp, nov., formerly CDC group M-5, a gram–negative bacterium associated with dog bite wounds. J Clin Microbiol 1993 Sep; 31 (9): 2456-66.
5. Eiros J, Domínguez Gil M, Pellicer J. Celulitis por Neisseria weaveri tras mordedura de perro. Rev Esp Quimioter 2015; 28 (6): 322-3.
6. Almuzara M, Figueroa S, Palombarani S, Tuduri A, Petracini N. Infecciones por mordedura de perro asociadas a CDC grupo EF-4a. Comunicación de 2 casos. Enferm Infecc Microbiol Clin 1998; 16: 123.
7. Ujvari B, Orbán B, Incze Z, Psáder R, Magyar T. Ocurrence of Pasteurellaceae and Neisseriaceae bacteria in the pharyngeal and respiratory tract of dogs and cats - Short communication. Acta Vet Hung 2020; 68 (3): 231-5.
8. Capitini C, Herrero I, Patel R, Ishitani M, Boyce T. Wound infection with Nesisseriaweaveri and a novel subspecies of Pasteurella multocida in a child who sustained a tiger bite. Clin Infect Dis 2002 Jun 15; 34 (12): E74-6.
9. Goldstein E, Citron D, Tyrrell L, Leoncio E. In vitro activity of pexiganan and comparator antimicrobials against 234 isolates, including 93 Pasteurella species and 50 anaerobic bacterial isolates recovered from animal bite wounds. Antimicrob Agents Chemother 2017; 61 (6): 1-7.
10. Suárez-López A, Ruiz-Garbajosa P, Sánchez-Díaz A. Infección de herida por mordedura de gato. Enferm Infecc Microbiol Clin 2018 Mar; 36 (3): 194-5.
11. Almuzara M, Cárdenas KCV, Barberis C, Ramirez MS, Famiglietti A, Vay C. Performance of MALDI-TOF mass spectrometry for the identification of the HACEK group and other fastidious gram-negative rods. Open Microbiol J 2019; 13: 216-21.
Notas de autor
flaviamalfa@hotmail.com
